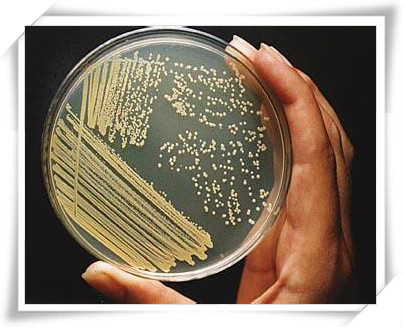

题目
实验十五 微生物的生理生化反应
详细内容
目的:掌握细菌鉴定中主要生理生化反应的常规试验法。
重点:掌握细菌鉴定中的糖发酵反应
内容:
实验十五 微生物的生理生化反应
由于各种细菌具有不同的酶系统,它们能利用的底物(如糖、醇及各种含氮物质等)不同,或虽利用相同的底物但产生的代谢产物却不同。因此,可用各种生理生化反应来鉴别不同(形态或其他方面不易区别)的细菌。如肠道细菌中,大肠杆菌和伤寒杆菌,二者在形态上不易区分,但前者能发酵乳糖,后者不能。因此,可以从它们能否发酵乳糖来区别它们。所以细菌的生理生化反应是细菌分类鉴定的重要依据之一。在肠杆菌科的鉴定中,生理生化反应试验常是区分种、属、族的重要依据。
指导:
一、糖发酵试验
原理
糖发酵实验是常用的鉴别微生物的生化反应,在肠道细菌的鉴定上尤为重要。绝大多数细菌都能利用糖类作为碳源和能源,但是它们在分解糖类物质的能力上有很大的差异。有些细菌能分解某种糖产生有机酸(如乳酸、醋酸、丙酸等)和气体(如氢气、甲烷、二氧化碳等);有些细菌只产酸不产气。例如大肠杆菌能分解乳糖和葡萄糖产酸并产气;伤寒杆菌分解葡萄糖产酸不产气,不能分解乳糖;普通变形杆菌分解葡萄糖产酸产气,不能分解乳糖。发酵培养基含有蛋白胨,指示剂(溴甲酚紫),倒置的德汉氏小管和不同的糖类。当发酵产酸时溴甲酚紫批示剂可由紫色(pH6.8)变为黄色(pH5.2)。气体的产生可由培养液中倒置的德汉氏小管的封闭端口中有无气泡有证明。
糖发酵实验是常用的鉴别微生物的生化反应,在肠道细菌的鉴定上尤为重要。绝大多数细菌都能利用糖类作为碳源和能源,但是它们在分解糖类物质的能力上有很大的差异。有些细菌能分解某种糖产生有机酸(如乳酸、醋酸、丙酸等)和气体(如氢气、甲烷、二氧化碳等);有些细菌只产酸不产气。例如大肠杆菌能分解乳糖和葡萄糖产酸并产气;伤寒杆菌分解葡萄糖产酸不产气,不能分解乳糖;普通变形杆菌分解葡萄糖产酸产气,不能分解乳糖。发酵培养基含有蛋白胨,指示剂(溴甲酚紫),倒置的德汉氏小管和不同的糖类。当发酵产酸时溴甲酚紫批示剂可由紫色(pH6.8)变为黄色(pH5.2)。气体的产生可由培养液中倒置的德汉氏小管的封闭端口中有无气泡有证明。
器材
1.菌种:大肠杆菌,普通变形杆菌。
2.培养基:葡萄糖发酵培养基
内容、步骤
1.用记号笔在各试管外壁上分别标明发酵培养基名称和所接种的细菌菌名。
2.取葡萄糖发酵培养基试管3支,分别接入大肠杆菌、普通变形杆菌,第三支不接种,作为空白对照。另取乳糖发酵培养基试管3支,同样分别接入大肠杆菌、普通变形杆菌,第三支不接种,作为空白对照。
注意:在接种后,轻缓摇动试管,使其均匀,防止倒置的小管进入气泡。
3.将接种过和作为对照的6支试管均置37℃培养24~48小时。
4.观察各试管的颜色变化及德汉氏小管中有无气泡。
二、产硫化氢试验
原理
硫化氢试验是检测硫化氢的产生,也是用于肠道细菌检查的常用生化试验。有些细菌能分解含硫的有机物,如胱氨酸、半胱氨酸、甲硫氨酸等产生硫化氢。硫化氢一遇培养基中的铅盐或铁盐等重金属盐类便形成黑色的硫化铅或硫化铁沉淀物,从而可断定硫化氢的产生与否。
以半胱氨酸为例,其化学反应过程如下:
CH2SHCHNH2COOH+H2O----CH3COCOOH+H2S +NH3
H2S+Pb(CH3COO)2----PbS +2CH3COOH
(黑色)
其测定方法有两种,一种是用含有柠檬酸铁铵的培养基穿刺培养,看是否有黑色沉淀(本实验采用);一种是在盛有液体培养基的试管中接种菌以后,在试管的棉塞下吊一片醋酸铅试纸,经培养后看醋酸铅试纸是否变黑。(醋酸铅试纸的制法:将普通滤纸浸在1%的醋酸铅溶液中,取出晾干,加压灭菌后,105℃烘干备用)。
器材
1.菌种:大肠杆菌,变形杆菌(或产气肠杆菌)。
2.培养基:硫化氢试验用培养基
内容、步骤
1.取硫化氢试验用培养基二支(内含柠檬酸铁铵,分别用穿刺接种法接种大肠杆菌和变形杆菌(或产气肠杆菌),试管上注明菌名,置37℃培养24小时。
2.培养后取出观察,看有无黑色沉淀产生。
大肠杆菌为阴性,变形杆菌或产气杆菌为阳性。
附:穿刺接种法:将已挑有菌的接种针(针必须很挺直),自培养基的中心垂直刺入培养基中,然后沿原穿刺线将针拔出,塞上棉塞,将接种针上残留的菌在火焰上烧掉。
三、吲哚试验
原理

吲哚试验是用来检测吲哚的产生。有些细菌能产生色氨酸酶,分解蛋白胨中的色氨酸产生吲哚和丙酮酸。吲哚与对二甲基氨基苯甲醛结合,形成玫瑰吲哚,此为红色化合物。但并非所有微生物都具有分解色氨酸产生吲哚的能力,因此吲哚试验可以作为一个生物化学检测的指标。
器材
1.菌种:大肠杆菌,产气杆菌
2.培养基、试剂:蛋白胨水培养基,乙醚,吲哚试剂(对二甲基氨基苯甲醛8克,95%乙醇760ml,浓HCl160ml)。
内容、步骤
1.取蛋白胨水培养基试管2支,分别接种大肠杆菌、产气杆菌,并在试管上注明菌名,置37℃培养48小时。
2.于培养2天后的蛋白胨水培养基内加3~4滴乙醚,摇动数次,静置1~3分钟,待乙醚上升后,沿试管壁徐徐加入2滴吲哚试剂,在乙醚和培养物之间产生红色环状物为阳性反应。
注意:加入吲哚试剂后不可再摇动,否则被混合,红色不明显。
大肠杆菌吲哚反应阳性,产气杆菌吲哚反应阴性。
四、明胶液化试验
原理
微生物可以利用各种蛋白质和氨基酸作为氮源,但当糖类物质缺乏时,亦可用它们作为碳源和能源。明胶是由胶原蛋白经水解产生的蛋白质,在25℃以下可维持凝胶状态,以固体形式存在。而在25℃以上明胶就会液化。有些微生物可产生一种称作明胶酶的胞外酶,水解这种蛋白质,而使明胶液化,甚至在4℃仍能保持液化状态。
器材
1.菌种:大肠杆菌,枯草杆菌,金黄色葡萄球菌。
2.培养基:明胶培养基
内容、步骤
1.取三支明胶培养基试管,用记号笔标明各管欲接种的菌名。
2.用接种针分别穿刺接种大肠杆菌、枯草杆菌、金黄色葡萄球菌。
3.将接种后的试管置20℃温箱中培养2~5天。
4.观察明胶液化情况及液化形状。
枯草杆菌为阳性,大肠杆菌为阴性,金黄色葡萄球菌为?。
五、V.P(乙酰甲基甲醇)反应
原理
V.P试验是用来测定某些细菌利用葡萄糖产生非酸性或中性末端产物的能力。如某些细菌生长于葡萄糖蛋白胨水培养基中能分解葡萄糖产生丙酮酸,而丙酮酸又可缩合、脱羧生成乙酰甲基甲醇,此化合物在碱性条件下能被空气中的氧气氧化成二乙酰。二乙酰与蛋白胨中精氨酸中的胍基作用,生成红色化合物地,称V.P反应阳性;不产生红色化合物者为阴性反应。有时为了使反应更为明显,可加入少量含胍基的化合物,如肌酸等。在试管中加入α-萘酚时,可促进反应出现。
器材
1.菌种:产气杆菌,大肠杆菌。
2.培养基、试剂:葡萄糖蛋白胨水培养基,40%KOH(NaOH),肌酸,α-萘酚溶液(5%α-萘酚酒精溶液:α-萘酚5克,溶于100ml无水乙醇中)
内容、步骤
1.接种与培养:将大肠杆菌和产气杆菌分别接种于装有葡萄糖蛋白胨水培养液的试管中,置37℃温箱培养24小时。
2.观察结果:取出培养好的试管,在培养基中加入40%的KOH溶液10~20滴,再加入等量的α-萘酚溶液,拔去棉塞,用力振荡,再放入37℃温箱中保温15~30分钟(或在沸水中加热1~2分钟)。如培养基出现红色,为V.P反应阳性。另还可以取一定量的培养液加入等量的40%KOH溶液,再加入0.5~1ml的肌酸,猛烈振荡的,2~10分钟内有红色出现即为V.P反应阳性。
产气杆菌为阳性,大肠杆菌为阴性。
六、甲基红(M.R)试验
原理
某些细菌在糖代谢过程中,将培养基中的糖先分解为丙酮酸,丙酮酸再被分解为甲酸、乙酸、乳酸等。使pH降低至4~5。有机酸的产生可由加入甲基红指示剂的变色进行检测。甲基红的变色范围为pH4.2(红)~6.3(黄)。细菌分解葡萄糖产酸,将培养基由原来的橘黄色变为红色,此为M.R正反应。
尽管所有的肠道微生物都能发酵葡萄糖产生有机酸,但这个试验在区分大肠杆菌和产气杆菌上仍然是有价值的。这两个细菌在培养的早期均产生有机酸,但大肠杆菌在培养后仍能维持酸性pH4,而产气肠杆菌则转化有机酸为非酸性末端产物,如乙醇、丙酮酸等,使pH升至大约6。
器材
1.菌种:产气杆菌,大肠杆菌。
2.培养基、试剂:葡萄糖蛋白胨水培养基,甲基红指示剂(甲基红0.02克、95%酒精60ml、水40ml。配时先将甲基红溶于酒精后再加水)。
内容、步骤
1.接种与培养:分别接种大肠杆菌和产气杆菌于装有葡萄糖蛋白胨培养液的试管中,置于37℃温箱中培养24小时。
2.观察结果:取出培养好的试管,沿管壁加入甲基红指示剂3~4滴,观察是否变色,若培养液由原来的橘黄色变为红色则为阳性反应。
大肠杆菌为M.R阳性反应,产气肠杆菌为M.R阴性反应。
七、柠檬酸盐利用试验
原理
肠杆菌科各属细菌利用柠檬酸的能力不同,有的菌可利用柠檬酸钠作为碳源,有的则不能。某些菌分解柠檬本酸形成CO2,由于培养基中钠离子的存在而形成碳酸钠,使培养基的碱性增加,pH升高,当加入1%溴麝香草酚蓝指示剂时,培养基就会由绿色变为深蓝色。溴麝香草酚蓝的指示范围为:pH小于6.0时呈黄色,pH在6.0~7.0时为绿色,pH大于7.6时呈蓝色。
器材
1.菌种:产气杆菌,大肠杆菌。
2.培养基、试剂:柠檬酸盐培养基
内容、步骤
1.接种与培养:将大肠杆菌和产气杆菌分别接种于柠檬酸盐培养基的斜面上,置于37℃温箱中培养48小时。
2.结果观察:培养基由绿色变为蓝色为阳性,绿色为阴性。
产气杆菌为阳性,大肠杆菌为阴性。
八、淀粉水解试验
原理
某些细菌可以产生水解培养基中淀粉的淀粉酶(胞外酶),使淀粉水解为麦芽糖和葡萄糖,再被细菌吸收利用。淀粉水解后,遇碘不再变蓝色。
器材
1.菌种:枯草杆菌,大肠杆菌。
2.培养基、试剂:淀粉培养基,碘液。
内容、步骤
1.将淀粉培养基在水浴中融化后,冷至50℃,以无菌操作制成平板。用接种环取少量枯草杆菌在平板的一边划“+”字形接种,另取少量大肠杆菌在平板的另一边接种。置37℃温箱中培养16~20小时。
2.观察结果:打开皿盖,滴加少量碘液于培养基上,轻轻旋转培养皿,使碘液均匀铺滿整个平板。如果在菌周围出现无色透明圈,说明淀粉被水解。透明圈的大小说明该菌水解淀粉能力的大小。
枯草杆菌反应为阳性,大肠杆菌反应为阴性。
实验报告
将实验结果填入下表。“+”表示阳性,“-”表示阴性,“+”表示产气
| 糖发酵 | 产硫化氢 | 吲哚试验 | 明胶液化 | V.P反应 | M.R试验 | 柠檬酸盐利用 | 淀粉水解 | |
| 大肠杆菌 | ||||||||
| 产气杆菌 | ||||||||
| 枯草杆菌 | ||||||||
| 变形杆菌 |
素材:
1.菌种:大肠杆菌,枯草杆菌,变形杆菌,产气杆菌,绿脓杆菌。
2.培养基:
◆ 糖发酵培养基
◆ H2S试验用培养基
◆ 蛋白胨水培养基(吲哚试验)
◆ 明胶培养基(明胶液化试验)
◆ 葡萄糖蛋白胨水培养基(V.P反应,甲基红试验)
◆ 柠檬酸盐培养基
◆ 淀粉培养基


